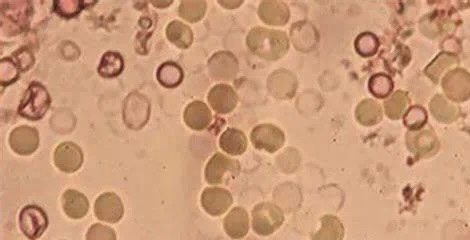
/private/var/mobile/Containers/Data/Application/4494A47D-7093-415A-A026-3639E797C8CB/tmp/insert_image_tmp_dir/2025-04-18 09:28:13.031000.png2025-04-18 09:28:13.031000

清晰透明。如果尿液颜色异常,可能提示不同疾病:红色可能提示血尿,常见于急性泌尿系感染、泌尿系统结石、肿瘤等。

尿蛋白
正常成人尿液中蛋白质阴性。正常尿液中仅有微量蛋白,尿蛋白定性试验呈阴性。如果尿蛋白阳性,可能是生理性的,如剧烈运动、发热等;也可能是病理性的,提示肾脏疾病。

尿潜血
正常尿液中尿潜血阴性,“+”号越多,意味着尿液里的红细胞含量越多,尿潜血的情况可能更严重。还有一种“假性潜血”,受女性经期、剧烈运动后、某些药物影响而产生,所以因为这三种情况出现的尿潜血阳性不用太担心。

尿糖
正常情况下,尿糖定性试验为阴性。当血糖浓度升高时,肾小球滤过葡萄糖量超过肾小管重吸收的最大能力,即可出现尿糖,定性检查为阳性,常见于糖尿病患者

除此之外,尿常规里还有一些我们不可忽视的指标
红细胞
正常成人尿液中红细胞小于3个/HP。红细胞数量增多,则提示机体存在泌尿系统炎症、结石、肿瘤等疾病的可能
白细胞
正常成人尿液中白细胞小于5个/HP。白细胞数量增多,则提示机体存在泌尿系统感染、炎症等

管型
正常成人尿液中管型阴性。如果发现管型阳性,则提示机体存在肾脏疾病、泌尿系统梗阻等疾病

结晶体
正常成人尿液中结晶体阴性或少量。结晶体增多,则提示机体存在代谢紊乱、结石等。

酸碱度
即尿的pH值,可反映肾脏调节体液酸碱平衡的能力。正常成人尿液酸碱度在4.6至8.0之间。酸碱度数值变化与饮食习惯有关,也可能受药物影响。

尿比重
反映肾脏浓缩功能,正常成人尿比重在1.015至1.025之间。饮水量的多少也会导致尿比重变化。

所以,尿常规虽然只是一项简单的检查,但它却像一面镜子,能够反映出我们身体的健康状况。
化验单是健康的“晴雨表”,但并非唯一标准。理性看待数据,与医生充分沟通,才是科学应对之。